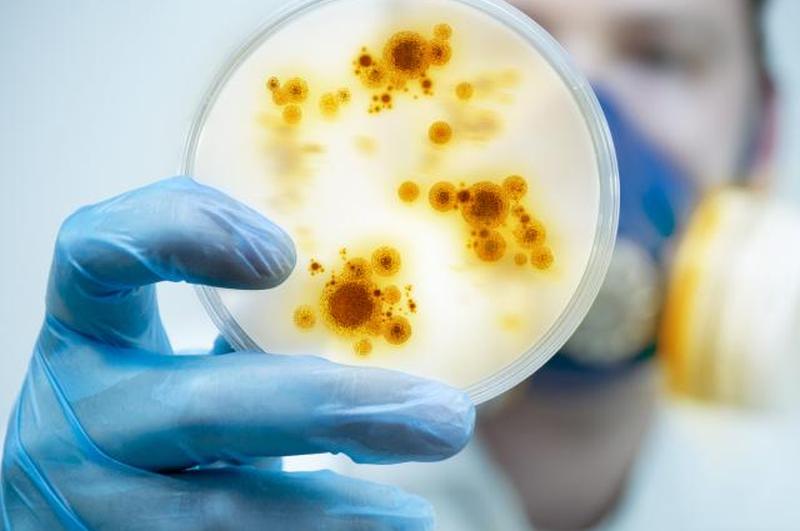
Патология

Судебная экспертиза — это захватывающая область, которая охватывает множество дисциплин. Стаффордширский университет отмечает, что криминалистической по своей природе науку делает то, что она используется в целях закона. Это означает, что аналитическая наука, используемая и собранная в качестве доказательства, может быть представлена в суд в любом случае, когда это требуется, чтобы суд полагался на беспристрастные эмпирические доказательства.
Чем на самом деле занимаются судебные медики?
Судебная медицина может охватывать несколько различных научных дисциплин, от химии до биологии и даже энтомологии. Независимо от типа судмедэксперта и ее дисциплины, по данным Академии судебных наук , есть несколько основных вещей, которыми занимаются все судебно-медицинские эксперты :
- Проанализируйте доказательства, чтобы определить их релевантность
- Проведите тесты на доказательствах
- Напишите краткие отчеты о проведенных экспериментах и объясните, как был получен вывод
- Давать показания в суде в качестве свидетеля-эксперта, не только сообщая факты, но и разъясняя суду, что означают факты.
Типы криминалистики
Существует несколько различных способов применения следователями своих научных знаний к уголовным делам. В то время как телевидение может заставить вас поверить, что все эти профессии имеют дело с трупами, судебная медицина на самом деле охватывает множество дисциплин и используется по-разному.
Судебная антропология
Судебные антропологи анализируют скелетные системы и используют методы археологии для раскрытия уголовных дел. Их часто вызывают на место, где находят человеческие останки. Изучая останки, они могут определить, кто умер, как они умерли и как давно они умерли. Как подготовленные археологи, судебные антропологи также помогают следователям раскапывать останки скелетов и тщательно записывать улики. Известные примеры этого типа криминалистики включают:
- Судебные антропологи помогли выяснить, как был убит Джон Ф. Кеннеди.
- После 11 сентября пришли судебные антропологи, чтобы помочь опознать жертв, проанализировав останки скелетов.

Судебная биология
Судебная биология применяет науку биологии к судебной экспертизе, чтобы помочь раскрыть преступления. Судебная биология включает дисциплины антропологии, энтомологии, патологии и ботаники. Хотя эти специальные ученые часто занимаются преступлениями, они также могут иметь дело с угрозами общественному здоровью, исследуя загрязнение окружающей среды. Чаще всего вы слышали о судебных биологах, использующих доказательства ДНК для раскрытия дел.
- Одним из примеров является случай с ногами, которые постоянно выбрасывались на берег . После тестирования ДНК исследователи смогли связать ноги с людьми, которые были в депрессии. Отсюда следователи пришли к выводу, что эти люди покончили жизнь самоубийством, спрыгнув с близлежащего моста, и отрубание их ног произошло как часть нормального процесса разложения.
- Анализ ДНК также использовался для установления личности бостонского душителя примерно через 50 лет после смерти его жертвы, Мэри Салливан.
Судебная ботаника
Судебные ботаники используют науку о растениях для раскрытия преступлений. Их основная цель — связать улики с конкретным местом преступления, используя свои знания в области науки о растениях, но наука о растениях также может помочь установить время смерти или найти скрытые могилы. Известные случаи, когда ботаника раскрыла преступление, включают:
- Во время суда над Бруно Рихардом Гауптманом , который похитил ребенка Линдберга, эксперт-ботаник смог связать дерево на лестнице, использованной в преступлении, с деревом рядом с домом Гауптмана и внутри него, изучив узоры колец в дереве и идентифицировав его. виды древесины.
- В деле об убийстве Дэви ботаники смогли сопоставить дерево с заднего двора убийцы с растительным материалом, найденным рядом с частями тела жертвы.
Судебная химия
Судебные химики обычно работают в лаборатории, чтобы сопоставить улики с известными веществами, чтобы помочь идентифицировать детали места преступления. Судебно-медицинский химик может проводить тесты на тканях и жидкостях организма, чтобы определить наличие наркотиков или других веществ в момент смерти. Они также могут анализировать органические и неорганические вещества с места преступления, чтобы попытаться идентифицировать вещества или объяснить, что произошло во время преступления. Примеры известных приложений включают:
- Полиция может использовать судебного химика для выявления наркотика, например, в деле против торговца кокаином Рафаэля Муньоса Талавера .
- Работая с полицейскими уликами, судебный токсиколог смог раскрыть убийство Кэрол Хеллар , отравившейся антифризом.
Судебная стоматология
Чаще всего судебный стоматолог использует зубы, чтобы идентифицировать людей. Стоматологи могут помочь установить факты, используя зубы умершего человека, но чаще они определяют следы укусов на жертвах и сопоставляют эти следы укусов с предполагаемыми преступниками. Примеры судебной стоматологии включают:
- Вероятно, самым известным примером использования следов укусов для идентификации преступника является пример Теда Банди . Он укусил двух своих жертв, и прокуратура попросила одонтологов проанализировать следы укусов и зубы Банди, чтобы определить его вину.
- След укуса был компроматом в деле Меган Канка, чье дело вдохновило на создание Закона Меган . Одонтологи смогли сопоставить след укуса, оставленный жертвой на руке ее убийцы.

Судебная энтомология
Судебные энтомологи являются экспертами в анализе того, как насекомые (и членистоногие) взаимодействуют с человеческими останками. Энтомологические данные могут помочь следователям сказать, когда человек умер, перемещали ли тело, а иногда даже как человек умер. Эксперты также проанализировали останки насекомых в автомобиле, чтобы определить путь, по которому он поехал перед аварией. Вот несколько примеров судебной энтомологии в действии:
- Кевин Нил сообщил о пропаже своих детей и защитил свою невиновность, заявив, что он не мог убить своих детей, так как находился в тюрьме. Однако энтомологи смогли сузить время смерти и, следовательно, доказать, что он не находился в тюрьме, когда были убиты его дети.
- Следователи подозревали Винсента Бразерса в убийстве жены, свекрови и детей. Однако у него было твердое алиби, отметив, что он никогда не путешествовал и поэтому не мог присутствовать на месте убийства. Однако энтомолог проанализировал мертвых жуков в решетке его автомобиля, поместив его в тот же регион, что и убийства.
Судебно-медицинская эпидемиология
Первоначально предназначенная для помощи в расследовании биотерроризма, судебная эпидемиология расширилась и теперь включает широкий спектр приложений. Судебные эпидемиологи используют систематическую методологию, чтобы определить, является ли использование биологических или химических агентов преступным деянием. Некоторые из наиболее широко известных примеров судебной эпидемиологии включают:
- Александр Литвененко поступил в больницу с жалобами на проблемы с желудком. Его предположение о том, что кто-то пытался убить его, в значительной степени было проигнорировано. Однако по мере того, как ему становилось хуже, врачи проверили его и обнаружили в его моче плуноний-210. Дальнейшее тестирование показало, что чайник в отеле, где он останавливался, также дал положительный результат на это вещество… и постоянно использовался, потенциально заражая гораздо больше людей.
- Эпидемиологи также помогают отслеживать вспышки , такие как сальмонеллез, чтобы увидеть, где начинается заражение. В 2009 году произошла вспышка сальмонеллеза в нескольких штатах, которую исследователи связали с арахисовым маслом.
Судебная геология
Судебные геологи применяют науку о Земле в судебных делах. Чаще всего они сопоставляют материалы земли, такие как почва или камень, найденные на «рецепторе» (жертве, машине и т. д.), с местом преступления. Одним из таких примеров является исчезновение сотрудника Агентства по борьбе с наркотиками Кики Камераны . Сначала ученые взяли образцы земли с тела Камарены, заподозрив, что это нечестная игра. Затем они сопоставили образцы с потенциальными местами, где могла произойти его смерть, и после тщательного анализа обнаружили, что тело действительно было перемещено посмертно. Эти доказательства разоблачили сокрытие со стороны мексиканского правительства и в конечном итоге привели к осуждению виновных.

Морская криминалистика
Морская криминалистика занимается научным анализом морских видов. Эта область возникла, когда в 1970-х годах правительство приняло закон, защищающий рыболовство, морских млекопитающих и исчезающие виды. Судебно-медицинский эксперт может помочь следователям определить, откуда взялся тот или иной вид и находится ли он под угрозой исчезновения. Примеры дел, раскрытых морской криминалистикой, включают:
- Морские судмедэксперты будут тестировать ДНК акулы, чтобы определить, был ли акульий плавник, используемый в определенных кухнях, получен незаконным путем. Кроме того, они также проверят ДНК образцов филе, чтобы определить, является ли рыба охраняемым видом.
- Другой пример связан с утоплением . Ученые будут искать присутствие диатомовых водорослей, чтобы определить, была ли жертва утоплена или убита, а затем брошена в воду.
Судебная метеорология
Криминалисты-метеорологи используют свой опыт, связанный с погодой, чтобы помочь в страховых претензиях и других юридических спорах. Например:
- Есть юридический случай, когда после сильного шторма и значительного материального ущерба судебные метеорологи пытаются помочь страховым компаниям определить, несут ли они ответственность за ущерб, поскольку полисы могут покрывать ущерб от одного инцидента, связанного с погодой, но не другого.
- У главного подозреваемого было алиби — он сказал, что катается на сноуборде. Однако судебные метеорологи опровергли его рассказ о сноуборде, отметив, что в то время, когда, по его словам, он катался на сноуборде, на самом деле шел дождь, а снега не было.
Судебная патология
Судебно-медицинские патологоанатомы помогают определить информацию о жертве или преступлении путем осмотра трупа. Многие люди знакомы с судебной патологией, потому что эти ученые также известны как судмедэксперты. Медицинские эксперты часто используются для определения причины смерти и того, как умерла жертва, и при этом могут предположить, был ли умерший жертвой убийства. Согласно WebMD , вскрытие может проводиться:
- Чтобы обнаружить ранее не диагностированное заболевание
- Если есть вопросы о том, как человек умер
- Если родственники требуют вскрытия для выявления каких-либо генетических заболеваний
- Когда смерть наступила во время медицинской процедуры, но была неожиданной
- Если смерть может повлиять на другие юридические вопросы (например, условия завещания, гражданское дело и т.
Следовательно, существует множество дел, в которых используются показания судебно-медицинского эксперта, от убийства до злоупотребления служебным положением.
Судебная экспертиза дикой природы
Судебно-медицинские эксперты по этой специальности сосредотачиваются на судебно-медицинских доказательствах нечеловеческого происхождения, чтобы помочь определить, был ли нарушен закон о дикой природе. Судебно-медицинские эксперты по дикой природе могут анализировать улики, чтобы помочь поймать браконьеров , помочь остановить незаконную торговлю слоновой костью и аналогичные преступления против дикой природы.
Судебная экспертиза завораживает
Судебная медицина увлекательна и может включать в себя широкий спектр дисциплин. Использование научных знаний для содействия правосудию и поимки преступников — это достойная карьера.

